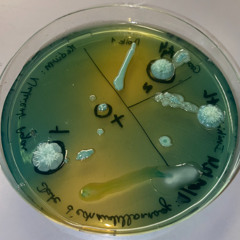
Nitrosomonas

Gloomy - Let's Take A Step
e-Gloomy-nations
282
3:42
Apr 26, 2022
14
15
2
Eurgh, I guess this isn't Hiphop, is it? Or just Hiphop Gloomy-style. I'm still working on this track, so anything can change. What do you think of it? How can I make it better? Thanks in advance you sweet people.
Under…
Recent comments
White Rabbit
· 3ygreat, dark sounds
Serzh83
· 3ycool sound, more ambient and dark atmosphere in track, thanx…
e-Gloomy-nations
· 3y@user-979727495-859914578: Thanks for visiting my page!
Fred-E Skywalker
· 3yLeuk gedaan!